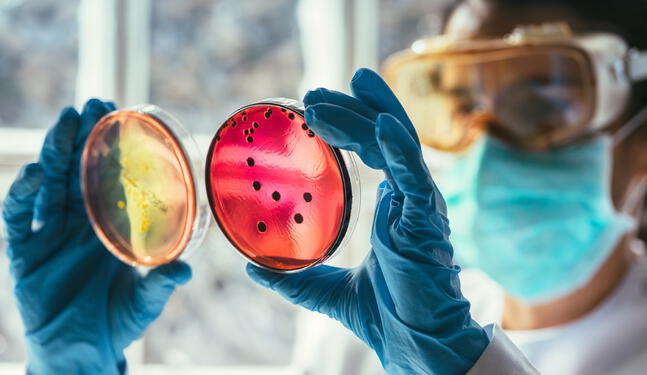

Durante la Mañanera del Pueblo, el director del Fondo de Cultura Económica (FCE), Paco Ignacio Taibo II, presentó los avances de la nueva política lectora que impulsa el organismo, enfocada en democratizar el acceso a la lectura sin sacrificar la calidad editorial.
Como parte de esta estrategia, anunció el programa “25 para 25”, con el que se pretende regalar 2.5 millones de libros antes de que termine el año en varios países de Latinoamérica, seleccionando obras de 25 autores distintos.
Taibo II destacó que el FCE no sólo produce libros, sino que opera como una red comercial que distribuye títulos de diversas editoriales. A la fecha, el Fondo ha producido 21 millones de libros y vendido 24 millones de ejemplares, incluyendo 3 millones de la colección Vientos del Pueblo, que ofrece títulos a precios accesibles, entre 11 y 20 pesos.
Actualmente, el FCE opera 109 librerías en México y 21 en el extranjero, y tiene presencia en más de 100 ferias del libro nacionales e internacionales. También ha logrado una sostenibilidad financiera, a diferencia de los déficits con los que operaba en gobiernos anteriores.
Además, cuenta con 21 mil 118 salas de lectura registradas y participa en diez programas de difusión en medios públicos.
La presidenta Claudia Sheinbaum reconoció el trabajo de Taibo II al frente del Fondo y reveló que su libro favorito es Cien años de soledad, del colombiano Gabriel García Márquez.